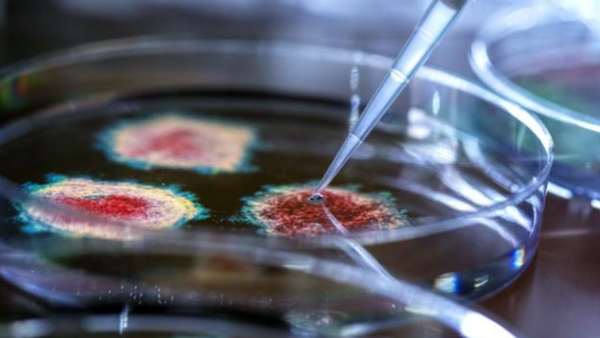
நெதர்லாந்து, இங்கிலாந்து

'ஆபத்தான நாடுகளிலிருந்து' இந்தியா வந்த 6 பயணிகளுக்கு கொரோனா.. ஓமிக்ரான் பாதிப்பா? வைரஸ் மரபணு சோதனை
டெல்லி: "ஆபத்தில் உள்ள" பட்டியலிலுள்ள நாடுகளிலிருந்து இந்தியாவிற்கு வந்த விமானங்களில் 3,000 க்கும் மேற்பட்ட பயணிகளை பரிசோதனை செய்து பார்த்ததில், 6 கொரோனா கேஸ்கள் கண்டறியப்பட்டுள்ளன.
இவர்கள் Omicron வகை கொரோனாவால் பாதிக்கப்பட்டுள்ளார்களா என்பதை அறிய, பயணிகளின் பாசிட்டிவ் மாதிரிகள் ஜீனோமிக் சீக்வென்ஸ் பரிசோதனைக்கு அனுப்பப்பட்டுள்ளன.
நேற்று நள்ளிரவு முதல் மாலை 4 மணி வரை "ஆபத்தில் உள்ள" நாடுகளில் இருந்து மொத்தம் 11 சர்வதேச விமானங்கள் நாட்டின் பல்வேறு விமான நிலையங்களில் தரையிறங்கின. அதில் வந்த, அனைத்து 3476 பயணிகளுக்கும் RTPCR சோதனைகள் நடத்தப்பட்டன, அதில் 6 பயணிகளுக்கு கோவிட்-19 பாசிட்டிவ் இருப்பது கண்டறியப்பட்டது.
நெதர்லாந்து, இங்கிலாந்து
புதன்கிழமை அதிகாலை நெதர்லாந்து மற்றும் இங்கிலாந்திலிருந்து டெல்லி வந்த நான்கு பேர் கொரோனா பாசிட்டிவ் என உறுதி செய்யப்பட்டுள்ளனர். ஒமிக்ரான் என்ற புதிய திரிபு காரணமாக அவர்கள் பாதிக்கப்பட்டுள்ளார்களா என்பதை கண்டறிய அவற்றின் மாதிரிகள் மரபணு வரிசைப்படுத்தலுக்கு அனுப்பப்பட்டுள்ளன.

ஆய்வகங்கள்
கோவிட்-19 பாசிட்டிவ் பயணிகளின் மாதிரிகள் முழு ஜீனோமிக் சீக்வென்சிங்கிற்காக INSACOG ஆய்வகங்களுக்கு அனுப்பப்பட்டுள்ளன. சூழ்நிலையை உன்னிப்பாக கவனித்து வருகிறோம் என்று மத்திய அரசு தெரிவித்துள்ளது.

மத்திய பிரதேசம்
இதற்கிடையில், மத்தியப் பிரதேசத்தின் இந்தூரில் உள்ள சுகாதாரத் துறை கடந்த ஒரு மாதமாக வெளிநாட்டில் இருந்து திரும்பிய 100 பேரைத் தேடி வருகிறது. "இதுவரை, கடந்த ஒரு மாதத்தில் வெளிநாட்டிலிருந்து இந்தூர் திரும்பிய சுமார் 150 பேரில் 50 பேரை நாங்கள் கண்டுபிடித்துள்ளோம். கண்டுபிடிக்கப்பட்ட 50 நபர்களின் மாதிரிகள் பரிசோதிக்கப்பட்டன, அவர்களில் யாருக்கும் கோவிட் -19 தொற்று இல்லை. மீதமுள்ள 100 பேரின் மாதிரிகள் சேகரிக்கப்பட்டு பரிசோதிக்கப்படும்" என்று தலைமை மருத்துவ மற்றும் சுகாதார அதிகாரி டாக்டர் பிஎஸ் சைத்யா பிடிஐயிடம் தெரிவித்துள்ளார்.
Recommended Video

மகாராஷ்டிரா
ஞாயிற்றுக்கிழமை, மத்திய அரசு சர்வதேச பயணிகளுக்கான புதிய வழிகாட்டுதல்களை வெளியிட்டது, நே்று டிசம்பர் 1 முதல் நடைமுறைக்கு வந்தது. 'ஆபத்திலுள்ள நாடுகளில்' இருந்து மும்பைக்கு வரும் சர்வதேச பயணிகளுக்கு 7 நாள் கட்டாய தனிமைப்படுத்தலை மகாராஷ்டிரா அரசு அறிவித்துள்ளது. மேலும், 2, 4 மற்றும் 7 ஆகிய நாட்களில் RT-PCR சோதனைகள் மேற்கொள்ளப்படும், சோதனைகளில் ஏதேனும் நேர்மறையாக இருப்பது கண்டறியப்பட்டால், பயணிகளை மருத்துவமனைக்கு மாற்ற வேண்டும்.












Click it and Unblock the Notifications